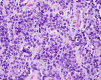

A Puzzling Case of Pouch Pathology
- PMID: 34840993
- PMCID: PMC8613351
- DOI: 10.14309/crj.0000000000000669
A Puzzling Case of Pouch Pathology
Abstract
A 36-year-old man with familial adenomatous polyposis secondary to an adenomatous polyposis coli mutation status post proctocolectomy with ileal pouch-anal anastomosis presented with hematochezia. Pouchoscopy revealed a 4-cm indurated mass in the distal ileal pouch just 17 months after a normal pouchoscopy. Histopathology was diagnostic for Burkitt lymphoma, and the patient achieved complete remission with subsequent chemotherapy. Although there are reports of Burkitt lymphoma in patients with ileal pouch-anal anastomosis, to date, this is the first report in a patient with familial adenomatous polyposis. This case highlights the presentation of a rapidly enlarging tumor not commonly seen in the adult gastroenterology population.
© 2021 The Author(s). Published by Wolters Kluwer Health, Inc. on behalf of The American College of Gastroenterology.
Figures

References
-
- Smart CJ, Gibb A, Radford J. Burkitt's lymphoma of an ileal pouch following restorative proctocolectomy. Inflamm Bowel Dis. 2012;18(8):E1596–E1597. - PubMed
-
- Kariv R, Remzi FH, Lian L, et al. Preoperative colorectal neoplasia increases risk for pouch neoplasia in patients with restorative proctocolectomy. Gastroenterology. 2010;139(3):806–2. - PubMed
Publication types
LinkOut - more resources
Full Text Sources

